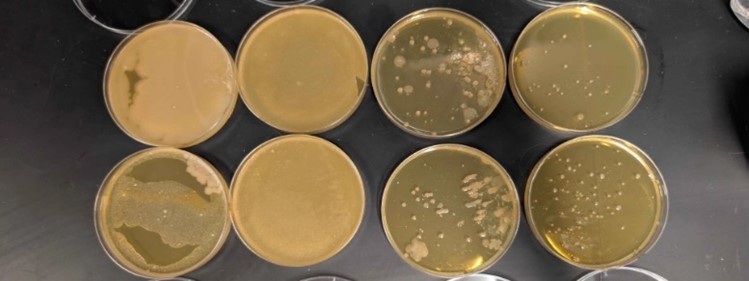

Comprehensive Evaluation of Advanced Water Filtration Techniques: Assessing Efficacy in Removing Hazardous Contaminants and Inhibiting Bacterial Proliferation
DOI:
https://doi.org/10.70844/ijas.2025.2.33Keywords:
- Biodegradability,
- Chemicals,
- Filtration,
- Sustainability,
- Water use
Abstract
Access to clean drinking water is a fundamental necessity, yet water contamination remains a pressing global concern. This study investigates the effectiveness of various filtration methods in removing harmful contaminants—primarily nitrates, nitrites and sulfates—from water sources while assessing bacterial presence post-filtration. We designed an innovative, eco-friendly and cost-efficient filtration system and compared its performance against conventional filtration methods, including reverse osmosis, activated carbon and LifeStraw filters.
Our results demonstrated that the newly designed filtration system effectively reduced nitrate, nitrite and sulfate concentrations while minimizing bacterial presence. Contrary to prior assumptions, our study did not evaluate E. coli survival and reproduction but instead focused on culturing and quantifying bacteria already present in the water samples. The findings indicate that the eco-friendly filtration system outperforms traditional methods in improving water safety, making it a viable solution for communities with limited access to clean drinking water.
Downloads
References